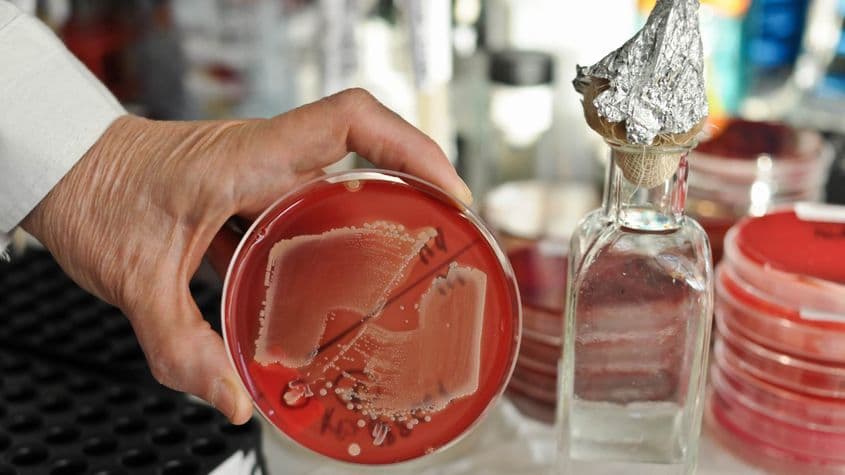

Ce s-a întâmplat la Spitalul de Pediatrie din Piteşti e relevant pentru criza sistemului de sănătate. Foto: Lucian Muntean

Ce s-a întâmplat la Spitalul de Pediatrie din Piteşti e relevant pentru criza sistemului de sănătate. Foto: Lucian Muntean
25/02/2016
300. Luptătorii care lipsesc în linia întâi a sistemului medical
Țara noastră poate deveni furnizoare de expertiză pe arii de performanță cum sunt sistemul de supraveghere a gripei, sistemul de urgență sau legislația antifumat.
După #Colectiv, o asemenea declarație pare greu de crezut. Totuși, ea a fost făcută chiar de șeful statului, într-o dezbatere pe teme de sănătate desfășurată miercuri, 24 februarie, la Palatul Cotroceni.
În consecință, îi propunem președintelui Iohannis următoarea problemă concretă:
Dacă statul român e performant în situații de urgență, cum de nu știm cauza morții celor trei copii din Argeș diagnosticați cu sindrom hemolitic-uremic (SHU)?
… precum și o problemă structurală:
Dacă putem da lecții altor țări în ceea ce privește supravegherea gripei, cum se explică lipsa din sistemul de sănătate a cel puțin 300 de medici epidemiologi, cei care constituie linia întâi în prevenirea și gestionarea unor astfel de situații?
"Situația este inacceptabilă"
Potrivit unei evaluări a Societății Române de Epidemiologie (SRE), doar 200 de medici epidemiologi profesau în țară la finalul lui 2015. Dintre aceștia, aproape jumătate se află în Capitală.
Raportați acest număr la totalul de circa 460 de spitale publice și private.
„Sunt foarte multe spitale, inclusiv județene, dar și Direcții de Sănătate Publică care nu au nici măcar un medic epidemiolog. Situația este inacceptabilă”, spune președintele SRE, conf. dr. Emilian Damian Popovici.
Mulți ne citesc, puțini ne susțin. Fără ajutorul tău, nu putem continua să scriem astfel de articole. Cu doar 5 euro pe lună ne poți ajuta mai mult decât crezi și poți face diferența chiar acum!
Un caz concret: Spitalul de Pediatrie din Pitești, care a întârziat să raporteze cazurile de SHU către Direcția de Sănătate Publică Argeș, nu are medic epidemiolog.
Pentru finalizarea anchetei, care a început cu un decalaj de o săptămână, a fost nevoie de o echipă de experți suedezi, de la Centrul European de Control al Bolilor Infecțioase. Ai noștri n-au ajuns la vreo concluzie după mai bine de trei săptămâni de la înregistrarea primului caz de SHU.
Problemele sunt de ordin sistemic, este de părere ministrul Sănătății, Patriciu Achimaș-Cadariu.
„Ultimul eveniment din Argeș ne-a arătat că un întreg lanț de informații nu a funcționat. Neraportarea sau neatenția pot costa vieți. Nu e cazul de a compromite descentralizarea, dar asta nu înseamnă să ne abandonăm pacienții în locuri unde nu pot primi tratament adecvat”, le-a spus ministrul reprezentanților de la Direcțiile județene de Sănătate Publică convocați la videoconferință luni, 22 februarie.
O specialitate desființată și reînființată
EXCLUSIV: Noul ministru al Agriculturii a fost ofițer “Doi ș’un sfert”
Informația, care nu apare în CV-ul noului ministru al Agriculturii, a fost confirmată pentru PressOne din surse multiple din interiorul Ministerului de Interne, care au precizat că, la un moment dat, Chesnoiu a fost ofițerul din cadrul Direcției Generale de Protecție Internă (DGPI) care s-a ocupat de supravegherea Academiei de Poliție.
Parlamentare 2016: tinerii chiulesc, rezultatul e decis de segmentul 45-64 de ani
Dezinteresul tinerilor a făcut ca rezultatul alegerilor să fie hotărât mai ales de votanții cu vârste cuprinse între 45 și 64 de ani.
Care sunt consecințele lipsei de epidemiologi?
Președintele SRE, Emilian Damian Popovici, spune că cei aproximativ 200 de medici din această specialitate sunt plătiți foarte prost și nu se bucură de nici o recunoaștere.
„În responsabilitatea lor intră sănătatea populației, ceea ce nu e puțin. Răspund pentru supraveghere și inspecție și au inclusiv responsabilități economice, care nu țin de meseria de medic.”
Un newsletter pentru cititori curioși și inteligenți.
Sunt curios
Salariul unui epidemiolog începe de la circa 1.600 de lei, fiind similar cu leafa unui medic din specialitățile clinice. Numai că primul nu are parte de recompensa emoțională și materială de care beneficiază colegii săi care intră în contact cu pacienții.
Așa se face că, în România, epidemiologia a ajuns o Cenușăreasă a specialităților medicale.
În 2006, un Ordin al ministrului de atunci, Eugen Nicolăescu, desființa specialitatea de rezidențiat Epidemiologie, care ajungea să fie subsumată Sănătății publice și Managementului.
Un an mai târziu s-a revenit asupra deciziei, însă fără mari rezultate.
„În străinătate, acești specialiști fac parte din board-ul de conducere al spitalelor. La noi, și cei care fac rezidențiatul abandonează după un an, când văd despre ce e vorba”, a declarat pentru PressOne dr. Grațiana Chicin, membru al Comisiei Consultative de Epidemiologie din cadrul Ministerului Sănătății.
Ce face un epidemiolog
Epidemiologul unui spital e responsabil cu prevenirea și controlul infecțiilor cu bacterii nosocomiale. Apoi, potrivit legii, el „participă și supraveghează – în calitate de consultant – politica de antibiotico-terapie a unității și secțiilor”.
Acesta e un alt punct fierbinte al sistemului sanitar românesc. România a primit numeroase avertismente din partea forurilor internaționale pentru abuzul de antibiotice – care este una dintre cauzele ratei mari a infecțiilor nosocomiale.
Rolul epidemiologului este și de a supraveghea activitatea laboratorului de diagnostic pentru infecții. În cazul unei alerte, el coordonează ancheta, solicită și trimite tulpini de microorganisme izolate la laboratoarele de referință.
Legea obligă spitalele să angajeze medic epidemiolog, dată fiind importanța lor pentru sănătatea populației și, implicit, pentru siguranța națională.
În legislație, patru pagini sunt dedicate numai atribuțiilor medicului responsabil pentru supravegherea și controlul infecțiilor nosocomiale. În practică, numărul infecțiilor nosocomiale este micșorat în rapoartele oficiale.
„Atunci când se raportează o infecție nosocomială, cei care au raportat se trezesc cu un control, în loc să se trezească cu o recompensă că și-au făcut treaba. Așa că unii evită să facă anumite declarări, pentru că se așteaptă la repercusiuni”, a explicat președintele SRE pentru PressOne.
Managerii de spitale intră în această horă a minimalizării fenomenului, de teamă să nu le scadă punctajul de performanță.
Situația este confirmată de ultima evaluare realizată de Institutul Național de Sănătate Publică la cele 11 spitale din București care au primit răniți din #Colectiv. Controlul a fost efectuat după ce medici de la Spitalul de Arși recunoscuseră, în decembrie, că unele victime ale incendiului au murit din cauza infecțiilor intraspitalicești.
Ministerul Sănătății a întocmit, după #Colectiv, un plan de supraveghere a infecțiilor nosocomiale și de monitorizare a utilizării antibioticelor.
„În următoarele două luni vom face evaluări în 70 de spitale de urgență, institute și spitale mari. Vrem să dezvoltăm programul de supraveghere și control al infecțiilor nosocomiale, care în acest moment este un program restrâns”, declara, pe 8 februarie, conf. dr. Victor Strâmbu, secretar de stat în Ministerul Sănătății.
De 10 ori mai puțin în rapoarte
Estimări europene din ultimii 10 ani arată că între 5,5 și 7,5% din totalul pacienților internați contactează astfel de infecții de la bacterii intraspitalicești.
În România, raportările oficiale sunt de 0,2 – 0,25%. Date mai credibile pentru țara noastră au fost furnizate de un studiu european în 2012: 2,7%, ceea ce, potrivit Ministerului Sănătății, ar însemna circa 100.000 de cazuri anual.
Guvernul României a declarat ca prioritate îmbunătățirea capacității spitalelor de a detecta, supraveghea și controla infecțiile nosocomiale, precum și de a limita rezistența la antibiotice.
*
Trei dintre cei 12 copii internați în februarie cu sindrom hemolitic-uremic (SHU) la Spitalul „Marie Curie” din București au murit.
Una dintre posibilele erori de tratament a fost administrarea de antibiotice, care sunt contraindicate pentru că distrug pereții bacteriilor, eliberând în organism o cantitate mare de toxine.
Cum ar fi stat lucrurile dacă Spitalul din Pitești ar fi avut un epidemiolog?
ULTIMA ORĂ. Cu câteva ore înainte de publicarea acestui articol, Digi24 a difuzat un material despre un copil de un an și patru luni, tot din Pitești, care fusese plimbat timp de două săptămâni între mai multe unități din Capitală (Institutul „Matei Balș”, Spitalul „Grigore Alexandrescu”, Spitalul „Victor Babeș” și o clinică privată).
Pentru că nu au primit niciun diagnostic, în 22 februarie părinții s-au întors acasă cu copilul, însă starea lui nu s-a îmbunătățit.
Miercuri, 24 februarie, l-au dus din nou la Spitalul de Pediatrie din Pitești, în stare gravă, iar de acolo a fost trimis la Spitalul „Marie Curie”.
Avem nevoie de ajutorul tău!
Jurnalismul independent și de serviciu public nu se face cu aer, nici cu încurajări, și mai ales nici cu bani de la partide, politicieni sau industriile care creează dependență. Se face, în primul rând, cu bani de la cititori, adică de cei care sunt informați corect, cu mari eforturi, de puținii jurnaliști corecți care au mai rămas în România.
De aceea, este vital pentru noi să fim susținuți de cititorii noștri.
Dacă ne susții cu o sumă mică pe lună sau prin redirecționarea a 3.5% din impozitul tău pe venit, noi vom putea să-ți oferim în continuare jurnalism independent, onest, care merge în profunzime.
Share this